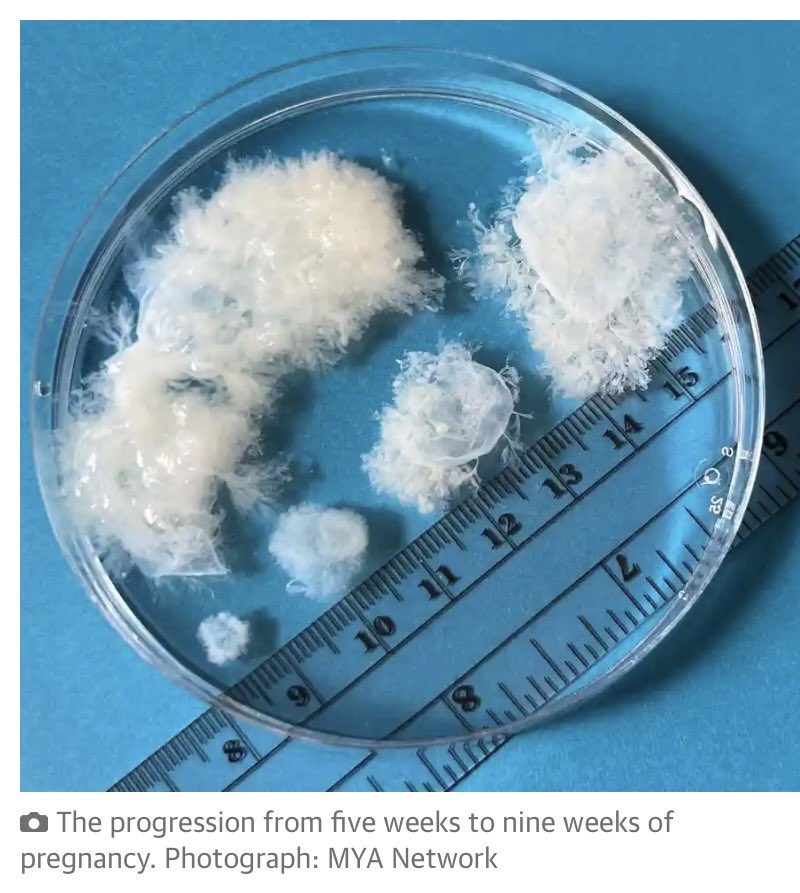
sally c (@sallyc8) on Twitter photo

sally c
@sallyc8
Go Blue, Bleed Blue, Vote Blue
ID: 595733119
31-05-2012 18:52:19
4,4K Tweet
73 Takipçi
251 Takip Edilen

.Thomas Massie is a lying, treasonous, boot licking worm. I have a message for him, if you agree with me RT this and let’s make sure he and the GQP see this video. #Airborne





Jo Anthony Scaramucci Wow, Jo, you're more ticked off than usual today. Yeah, we've all been ticked off for 8 years. If only we could get back the 8 years of our lives since Trump, or better yet, the 24 years of our life since the election was yanked from Al Gore with a SCOTUS 5-4 decision that